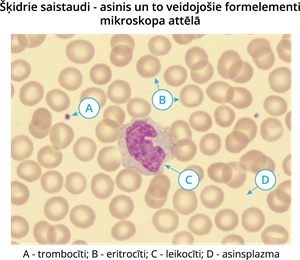
YCUZD_241009_6683_13.png

Audi ir nākošais dzīvības organizācijas līmenis pēc šūnām. Audi ir daudzšūnu organismiem- augiem un dzīvniekiem. Daudzšūnu sēnēm un aļģēm audu nav.
Dzīvnieku audi dalās patstāvīgajos jeb diferencētajos un nediferencētajos audos. Patstāvīgie audi ir epitēlijaudi, saistaudi, muskuļaudi un nervu audi.
Svarīgi!
Cilmes šūnas jeb mātšūnas ir dzīvnieku nediferencētas šūnas, tās var dalīties meitšūnās un diferencēties cita veida šūnās.
Zīdītājiem ir divu veidu cilmes šūnas – embrionālās un pieaugušo.
Embrionālās cilmes šūnas ir izolētas no iekšējās šūnu masas, un tās var iedalīt ektodermā, entodermā un mezodermā, un tās spēj veidot orgānus, kā arī atjaunot asinis, zarnas, ādu. Embrionālajā un zīdaiņu attīstības posmā ir visvairāk šo cilmes šūnu.
Cilmes šūnas var tikt noņemtas arī no nabas saites asinīm tikko pēc bērna dzimšanas. No visiem cilmes šūnu iegūšanas tipiem šis ir vismazāk bīstamākais, kā arī tā ir iespēja nodot šīs asinis asins bankā, lai nepieciešamības gadījumā tās varētu izmantot ķirurģiskām procedūrām.
Pieaugušo cilmes šūnas nodrošina organisma nemitīgu atjaunošanos. Tās ir atrodamas dažādos audos, visvairāk to ir sarkanajās kaulu smadzenēs, taukaudos un asinīs. Novecojot cilmes šūnu skaits organismā samazinās, tādēļ organisms nespēj atjaunot visas bojātās šūnas. Pieaugušo cilmes šūnas bieži tiek izmantotas dažādās medicīniskās terapijās, piemēram, kaulu smadzeņu transplantācijai leikēmijas gadījumā. Mūsdienās cilmes šūnas, izmantojot biotehnonoloģijas, var audzēt un pārveidot uz vajadzīgajiem šūnu tipiem. Embrionālās cilmes šūnas, kas iegūtas izmantojot somatisko šūnu kodola pārvietošanu, ir uzskatāma kā daudzsološa nākotnes terapija, lai ārstētu vai aizstātu bojātas šūnas un audus pacientiem.
Šūnas ir cieši saistītas cita ar citu, un starp tām nav šūnstarpu vielas. Izšķir segepitēliju un dziedzerepitēliju.
Cilmes šūnas var tikt noņemtas arī no nabas saites asinīm tikko pēc bērna dzimšanas. No visiem cilmes šūnu iegūšanas tipiem šis ir vismazāk bīstamākais, kā arī tā ir iespēja nodot šīs asinis asins bankā, lai nepieciešamības gadījumā tās varētu izmantot ķirurģiskām procedūrām.
Pieaugušo cilmes šūnas nodrošina organisma nemitīgu atjaunošanos. Tās ir atrodamas dažādos audos, visvairāk to ir sarkanajās kaulu smadzenēs, taukaudos un asinīs. Novecojot cilmes šūnu skaits organismā samazinās, tādēļ organisms nespēj atjaunot visas bojātās šūnas. Pieaugušo cilmes šūnas bieži tiek izmantotas dažādās medicīniskās terapijās, piemēram, kaulu smadzeņu transplantācijai leikēmijas gadījumā. Mūsdienās cilmes šūnas, izmantojot biotehnonoloģijas, var audzēt un pārveidot uz vajadzīgajiem šūnu tipiem. Embrionālās cilmes šūnas, kas iegūtas izmantojot somatisko šūnu kodola pārvietošanu, ir uzskatāma kā daudzsološa nākotnes terapija, lai ārstētu vai aizstātu bojātas šūnas un audus pacientiem.
Epitēlijaudi pārklāj visu ķermeni, kā arī izklāj iekšējos dobumus, veido dziedzerus.
Svarīgi!
Segepitēlija šūnas veic gan mehānisko aizsardzību, gan aizsargā pret ultravioleto starojumu, nodrošina vielu izdalīšanos un uzsūkšanos. Šūnas var būt gan vienā kārtā, gan daudzās kārtās.
Vienšūnas epitēlijs klāj galvenokārt iekšējos dobumus veidojot gļotādu, piemēram, gremošanas traktu, kur nepieciešama vielu uzsūkšanās, kapilāros, kā arī notiek vielu apmaiņa starp asinīm un audiem.
Skropstiņepitēlija šūnām ir diegveida izaugumi, kuri var, piemēram, viļņveidīgi kustēties, piemēram, elpceļos, vai palielināt uzsūkšanas virsmu, piemēram, tievajā zarnā.
Piemēram, sviedru dziedzeri izvada no organisma sviedrus, kuņģa dziedzeri ražo kuņģa sulu, kas palīdz sagremot uzturu, virsnieru dziedzeri izdala asinīs vielu (hormonu), kas paātrina sirdsdarbību.
Svarīgi!
Dziedzerepitēlijs veido dziedzerus, kuri var būt vienšūnas un daudzšūnu. Tie izdala dažādas vielas un sekrētus.
Muskuļaudi ir specializēti, sarauties spējīgi ķermeņa audi.
Tie sastāv no muskuļšūnām jeb miofibrillām, kuras satur sarauties spējīgas (kontraktīlas) šķiedras, kuras kustās cita gar citu, mainot šūnas izmēru. Šķiedras sastāv no tieviem un resniem olbaltumvielu - aktīna un miozīna pavedieniem. Tievajiem pavedieniem ievirzoties starp resnajiem pavedieniem, muskuļaudi saraujas. Saraujoties muskuļaudi patērē daudz enerģijas.

Šķērssvītrotie jeb skeleta muskuļaudi sastāv no garām, cilindriskām, savstarpēji paralēlām šķiedrām. Šķiedras veido šūnas, kurām izzudušas šķērssienas, un redzami daudzi kodoli. Šķērssvītrotie muskuļaudi veido skeleta muskuļus, nodrošina ķermeņa pārvietošanos. Šie audi pakļauti mūsu gribai.
Sirds muskuļaudi ir līdzīgi skeleta muskuļaudiem. Tie sastāv no vienkodola šūnām, kas savienojas savā starpā un izveido sietam līdzīgu veidojumu. Sirds muskuļaudi saraujas strauji, ritmiski, bet nav pakļauti mūsu gribai. Sirds muskuļaudi saraujas pašā sirdī radušos uzbudinājuma impulsu ietekmē.
Gludie muskuļaudi atrodas iekšējo orgānu sieniņās, tā nav pakļauta cilvēka gribai. To pamatvienība ir vārpstveida šūnas, kas pieguļ cieši viena otrai. Gludie muskuļaudi spējīgi saraujoties saīsināties līdz pat četrām reizēm. Muskuļšūnu kontrakcijas ir viļveidīgas, tās var būt sarautas ilgstoši.
Nervaudi ir specializēti audi uzbudinājuma vadīšanai.
Nervaudi sastāv no divu veidu šūnām - nervu šūnām jeb neironiem un neiroglijas jeb glijas šūnām, kas kopā darbojas kā nedalāma vienība.

Neironam jeb nervu šūnai ir ķermenis un vismaz viens izaugums. Izaugumu var būt arī daudz vairāk. Lai arī cik daudz nervu šūnai būtu izaugumu, viens no tiem ir aksons, bet visi pārējie – dendrīti. Aksons vada nervu impulsus no nervu šūnas ķermeņa uz citām nervu šūnām vai citu audu šūnām, ierosinot tajās sekrēta izdalīšanos vai muskuļu šķiedru saraušanos. Aksons ir garš, dažreiz pat 1-1,5 metrus garš. Dendrīti ir nervu šūnas jušanas izaugumi, tie vada nervu impulsus uz šūnas ķermeni. Dendrīti parasti ir īsi un atgādina zarotu koku. Nervu šūnu formu dažādība ir tik liela, ka visā nervu sistēmā nav divu pilnīgi vienādu nervu šūnu. Cilvēka smadzenēs ir ap 100 miljardu nervu šūnu.
Neiroglijas jeb glijas šūnas piešķir smadzenēm formu un blīvumu. Tās balsta nervu šūnas un to izaugumus, tām piemīt barošanas un aizsardzības funkcija, taču tās nespēj dot nervu impulsus.
Saistaudi ir audi, kas balsta un saista savā starpā epitēlijaudus, muskuļaudus un nervaudus.
Saistaudi atrodas visos orgānos, tāpēc to uzbūve ir ļoti dažāda, kā arī īpašības. Kopīga saistaudu pazīme ir šūnas, kas nepieguļ cita citai un starp tām ir daudz šūnstarpu viela, kas var būt gan cieta, gan šķidra, gan mīksta.
Šķidro saistaudu galvenā pazīme ir šķidra vide (plazma) starp šūnām. Asinis ir organisma šķidrie saistaudi, kas cilvēkam plūst tikai pa asinsvadiem. Tās organismā transportē skābekli, ogļskābo gāzi un barības vielas, hormonus, kā arī veido un transportē aizsargvielas. Limfai ir nozīmīga loma organisma šūnu un audu vielu maiņas un attīrīšanas procesos. Atšķirībā no asinsrites sistēmas, limfātiskā sistēma nav noslēgta un tai nav centrālā orgāna, kas to pārvieto. Limfa, kas cirkulē limfātiskajā sistēmā, pārvietojas ļoti lēni un zem maza spiediena.
Irdenie saistaudi pilda balsta funkciju un barošanas funkciju, jo ar šo audu starpniecību barojas citi audi. Tie ļoti labi atjaunojas un aizpilda ne tikai saistaudu, bet arī muskuļaudu bojājumus. Tādējādi šie saistaudi organismā rada rētaudus.
Irdenie saistaudi pilda balsta funkciju un barošanas funkciju, jo ar šo audu starpniecību barojas citi audi. Tie ļoti labi atjaunojas un aizpilda ne tikai saistaudu, bet arī muskuļaudu bojājumus. Tādējādi šie saistaudi organismā rada rētaudus.
Irdenie saistaudi sastopami visos orgānos. Tie var būt gan tuklās šūnas, kas veic imūnfunkcijas, gan pigmentšūnas u.c. Ādā irdenie saistaudi veido zemādu, citos orgānos - zemgļotādu. Irdenajos saistaudos sastopamas dažāda veida šūnas, ir plaša starpšūnu telpa, kas sastāv no amorfas pamatvielas, kolagēna un elastīgajām šķiedrām.

Taukaudu šūnas parasti ir apaļas, uzblīdušas, satur taukus. Kodoli un citoplazma ir atspiesti šūnas pretējā pusē. Taukaudi kalpo rezerves lipīdu uzkrāšanai, pasargā iekšējos orgānus no triecieniem un nodrošina termoizolāciju.
Cietie saistaudi veic daudzveidīgas funkcijas, piemēram, balsta funkciju, aizsargfunkcija, piesaistošā funkcija u.c. Galvenā šo audu pazīme ir šūnstarpu viela, kas satur kalcija u. c. sāļus un ir cieta. Šajos audos ir mazāk šūnu un vairāk šķiedru.

Kaulaudi balsta un aizsargā iekšējos orgānus un kopā ar muskuļiem nodrošina ķermeņa pārvietošanos. To šūnstarpu viela satur kalcija u. c. sāļus un ir cieta. Kaulu šūnas jeb osteocīti atrodas tālu viena no otras, tās izkārtojas koncentriskos apļos ap kaulu kanālu.
Skrimšļaudi ir izturīgi un elastīgi, to starpšūnu vielā ir daudz elastīgas šķiedras. Skrimšļaudi klāj garo kaulu galus, veido elpceļu gredzenveida skrimšļus, atrodas degunā, auss gliemežnīcās u.c.
Audu izvietojums organismā ir atkarīgs no to uzdevuma (funkcijām), ko tie veic.